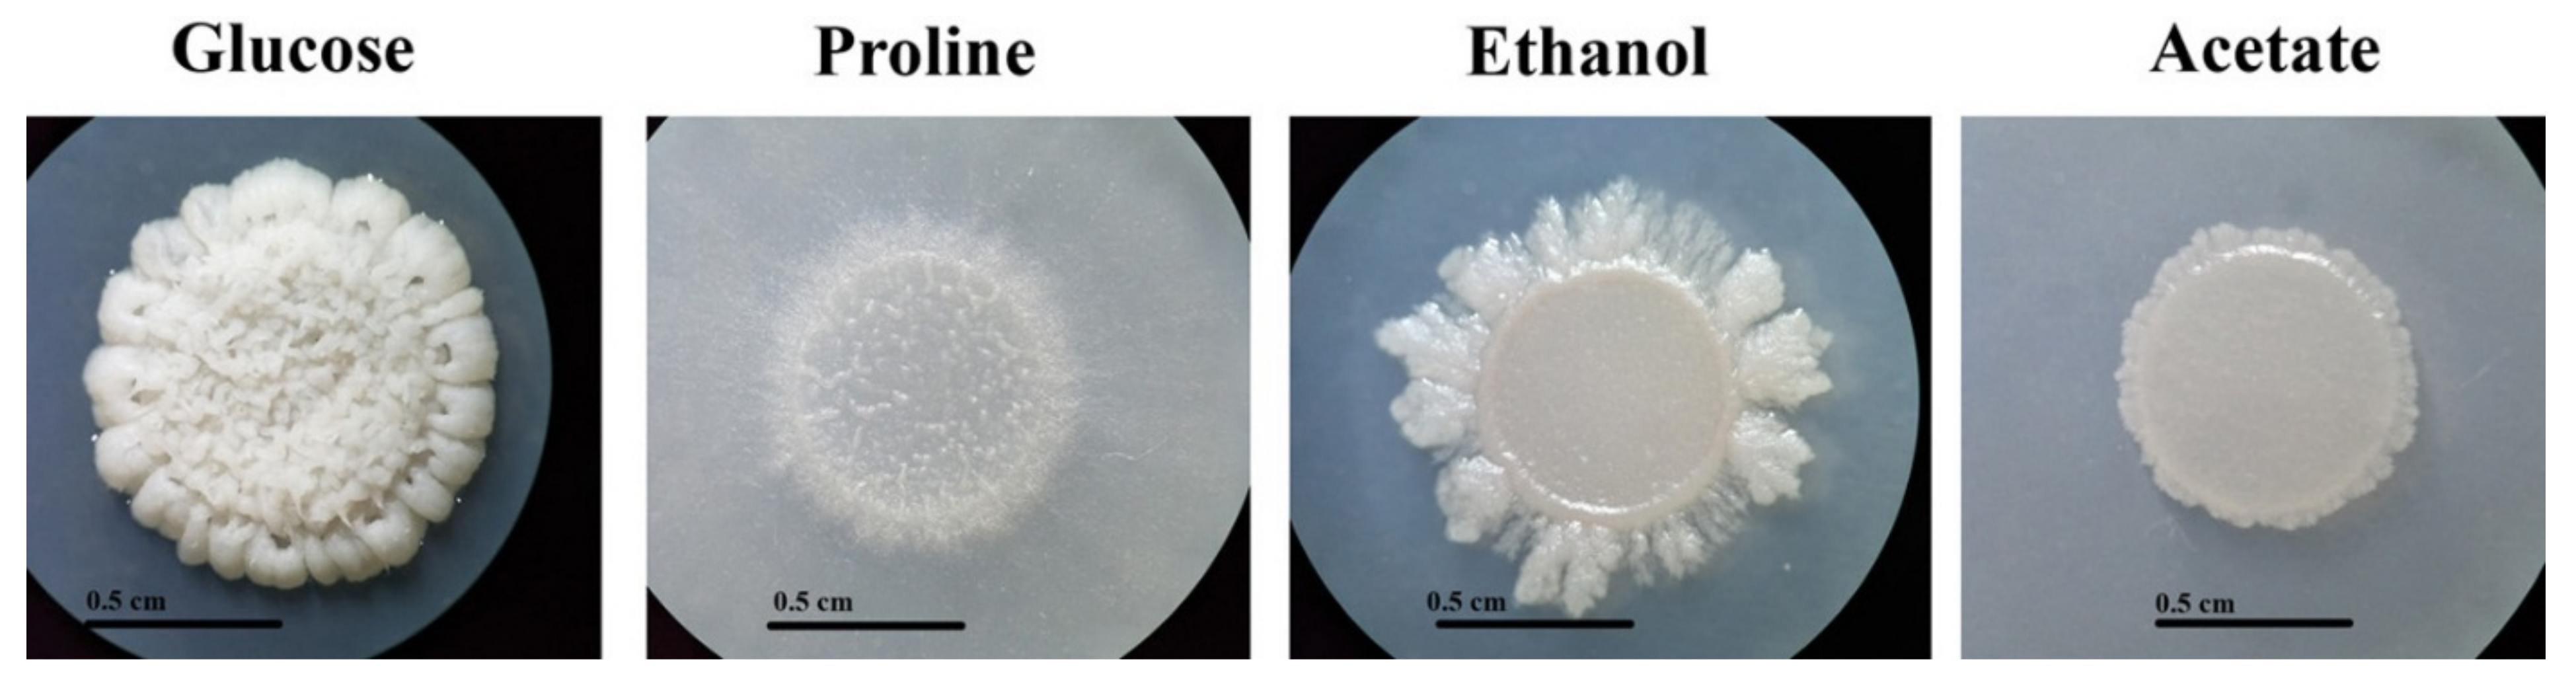
Jof 06 00102 g002

Expression of Talaromyces marneffei acuM and acuK Genes in Gluconeogenic Substrates and Various Iron Concentrations
Abstract
1. Introduction
2. Materials and Methods
2.1. Fungal Strain and Culture Conditions
2.2. RNA Isolation and cDNA Synthesis
2.3. Quantitative Real-Time PCR (qRT-PCR)
2.4. Statistical Analysis
2.5. Bioinformatics
3. Results
3.1. Growth of T. marneffei on Gluconeogenic Substrates
3.2. Growth of T. marneffei in Various Iron Concentrations
3.3. Expression of acuM and acuK in Gluconeogenic and Iron Conditions
4. Discussion
Supplementary Materials
Author Contributions
Funding
Acknowledgments
Conflicts of Interest
References
- Duong, T.A. Infection due to Penicillium marneffei, an emerging pathogen: Review of 155 reported cases. Clin. Infect. Dis. 1996, 23, 125–130. [Google Scholar] [CrossRef]
- Supparatpinyo, K.; Khamwan, C.; Baosoung, V.; Nelson, K.E.; Sirisanthana, T. Disseminated Penicillium marneffei infection in Southeast Asia. Lancet 1994, 344, 110–113. [Google Scholar] [CrossRef]
- Ene, I.V.; Brunke, S.; Brown, A.J.; Hube, B. Metabolism in fungal pathogenesis. Cold Spring Harbor Persp. Med. 2014, 4, a019695. [Google Scholar] [CrossRef]
- Hynes, M.J. Gluconeogenesis. In Cellular and Molecular Biology of Filamentous Fungi; Brokovich, K.A., Ebbole, D.J., Eds.; ASM Press: Washington, DC, USA, 2010; pp. 312–324. [Google Scholar]
- Sprenger, M.; Kasper, L.; Hensel, M.; Hube, B. Metabolic adaptation of intracellular bacteria and fungi to macrophages. Int. J. Med. Microbiol. 2017, 308, 215–227. [Google Scholar] [CrossRef] [PubMed]
- Barelle, C.J.; Priest, C.L.; Maccallum, D.M.; Gow, N.A.; Odds, F.C.; Brown, A.J. Niche-specific regulation of central metabolic pathways in a fungal pathogen. Cell Microbiol. 2006, 8, 961–971. [Google Scholar] [CrossRef] [PubMed]
- Lorenz, M.C.; Fink, G.R. The glyoxylate cycle is required for fungal virulence. Nature 2001, 412, 83–86. [Google Scholar] [CrossRef]
- Lorenz, M.C.; Bender, J.A.; Fink, G.R. Transcriptional response of Candida albicans upon internalization by macrophages. Euk. Cells 2004, 3, 1076–1087. [Google Scholar] [CrossRef]
- Liu, H.; Gravelat, F.N.; Chiang, L.Y.; Chen, D.; Vanier, G.; Ejzykowicz, D.E.; Ibrahim, A.S.; Nierman, W.C.; Sheppard, D.C.; Filler, S.G. Aspergillus fumigatus AcuM regulates both iron acquisition and gluconeogenesis. Mol. Microbiol. 2010, 78, 1038–1054. [Google Scholar] [CrossRef][Green Version]
- Pongpom, M.; Liu, H.; Xu, W.; Snarr, B.D.; Sheppard, D.C.; Mitchell, A.P.; Filler, S.G. Divergent targets of Aspergillus fumigatus AcuK and AcuM transcription factors during growth in vitro versus invasive disease. Infect Immun. 2015, 83, 923–933. [Google Scholar] [CrossRef]
- Hood, M.I.; Skaar, E.P. Nutritional immunity: Transition metals at the pathogen-host interface. Nat. Rev. Microbiol. 2012, 10, 525–537. [Google Scholar] [CrossRef]
- Hissen, A.H.; Wan, A.N.; Warwas, M.L.; Pinto, L.J.; Moore, M.M. The Aspergillus fumigatus siderophore biosynthetic gene sidA, encoding L-ornithine N5-oxygenase, is required for virulence. Infect. Immun. 2005, 73, 5493–5503. [Google Scholar] [CrossRef] [PubMed]
- Schrettl, M.; Haas, H. Iron homeostasis--Achilles’ heel of Aspergillus fumigatus? Curr. Opin. Microbiol 2011, 14, 400–405. [Google Scholar] [CrossRef] [PubMed]
- Pasricha, S.; Schafferer, L.; Lindner, H.; Joanne, B.K.; Haas, H.; Andrianopoulos, A. Differentially regulated high-affinity iron assimilation systems support growth of the various cell types in the dimorphic pathogen Talaromyces marneffei. Mole. Microbiol. 2016, 102, 715–737. [Google Scholar] [CrossRef] [PubMed]
- Canessa, P.; Larrondo, L.F. Environmental responses and the control of iron homeostasis in fungal systems. Appl. Microbiol. Biotech. 2013, 97, 939–955. [Google Scholar] [CrossRef]
- Gerwien, F.; Skrahina, V.; Kasper, L.; Hube, B.; Brunke, S. Metals in fungal virulence. FEMS Microbiol. Rev. 2018, 42, 1–21. [Google Scholar] [CrossRef]
- Haas, H. Iron - A Key Nexus in the Virulence of Aspergillus fumigatus. Front Microbiol. 2012, 3, 28. [Google Scholar] [CrossRef]
- Schrettl, M.; Kim, H.S.; Eisendle, M.; Kragl, C.; Nierman, W.C.; Heinekamp, T.; Werner, E.R.; Jacobsen, I.; Illmer, P.; Yi, H.; et al. SreA-mediated iron regulation in Aspergillus fumigatus. Mol. Microbiol. 2008, 70, 27–43. [Google Scholar] [CrossRef]
- Schrettl, M.; Beckmann, N.; Varga, J.; Heinekamp, T.; Jacobsen, I.D.; Jochl, C.; Moussa, T.A.; Wang, S.; Gsaller, F.; Blatzer, M.; et al. HapX-mediated adaption to iron starvation is crucial for virulence of Aspergillus fumigatus. PLoS Pathog. 2010, 6, e1001124. [Google Scholar] [CrossRef]
- Hynes, M.J.; Szewczyk, E.; Murray, S.L.; Suzuki, Y.; Davis, M.A.; Sealy-Lewis, H.M. Transcriptional control of gluconeogenesis in Aspergillus nidulans. Genetics 2007, 176, 139–150. [Google Scholar] [CrossRef]
- Suzuki, Y.; Murray, S.L.; Wong, K.H.; Davis, M.A.; Hynes, M.J. Reprogramming of carbon metabolism by the transcriptional activators AcuK and AcuM in Aspergillus nidulans. Mol. Microbiol. 2012, 84, 942–964. [Google Scholar] [CrossRef] [PubMed]
- Tam, E.W.; Tsang, C.C.; Lau, S.K.; Woo, P.C. Polyketides, toxins and pigments in Penicillium marneffei. Toxins 2015, 7, 4421–4436. [Google Scholar] [CrossRef] [PubMed]
- Baral, B.; Akhgari, A.; Metsa-Ketela, M. Activation of microbial secondary metabolic pathways: Avenues and challenges. Syn. Sys. Biotech. 2018, 3, 163–178. [Google Scholar] [CrossRef] [PubMed]
- Macheleidt, J.; Mattern, D.J.; Fischer, J.; Netzker, T.; Weber, J.; Schroeckh, V.; Valiante, V.; Brakhage, A.A. Regulation and role of fungal secondary metabolites. Annu. Rev. Genet. 2016, 50, 371–392. [Google Scholar] [CrossRef] [PubMed]

© 2020 by the authors. Licensee MDPI, Basel, Switzerland. This article is an open access article distributed under the terms and conditions of the Creative Commons Attribution (CC BY) license (http://creativecommons.org/licenses/by/4.0/).
Share and Cite
Pongpom, M.; Amsri, A.; Sukantamala, P.; Suwannaphong, P.; Jeenkeawpieam, J. Expression of Talaromyces marneffei acuM and acuK Genes in Gluconeogenic Substrates and Various Iron Concentrations. J. Fungi 2020, 6, 102. https://doi.org/10.3390/jof6030102
Pongpom M, Amsri A, Sukantamala P, Suwannaphong P, Jeenkeawpieam J. Expression of Talaromyces marneffei acuM and acuK Genes in Gluconeogenic Substrates and Various Iron Concentrations. Journal of Fungi. 2020; 6(3):102. https://doi.org/10.3390/jof6030102
Chicago/Turabian StylePongpom, Monsicha, Artid Amsri, Panwarit Sukantamala, Phimchat Suwannaphong, and Juthatip Jeenkeawpieam. 2020. "Expression of Talaromyces marneffei acuM and acuK Genes in Gluconeogenic Substrates and Various Iron Concentrations" Journal of Fungi 6, no. 3: 102. https://doi.org/10.3390/jof6030102
APA StylePongpom, M., Amsri, A., Sukantamala, P., Suwannaphong, P., & Jeenkeawpieam, J. (2020). Expression of Talaromyces marneffei acuM and acuK Genes in Gluconeogenic Substrates and Various Iron Concentrations. Journal of Fungi, 6(3), 102. https://doi.org/10.3390/jof6030102





